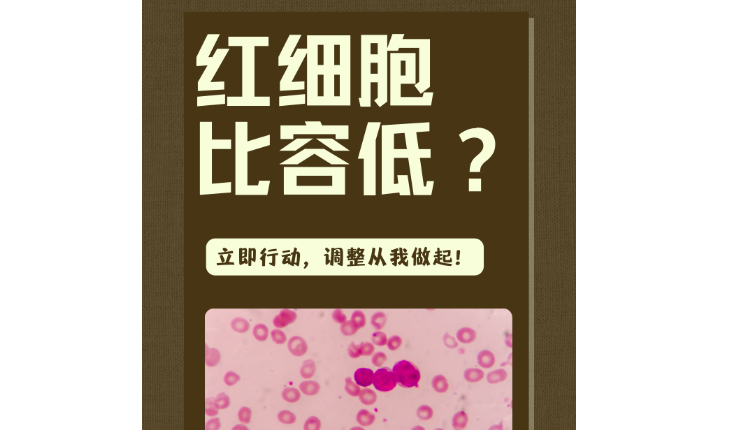

红细胞变异系数是临床上评价红细胞体积变异程度的指标,也叫红细胞平均体积(MCV)的标准差。通过测量红细胞的体积、长度和宽度等参数,并计算其变异系数,可以帮助医生判断疾病的类型和严重程度。然而,当红细胞变异系数偏低时,意味着什么呢?本文将详细解释这一现象的含义及其可能的原因。
一、红细胞变异系数偏低的含义
当红细胞变异系数偏低时,意味着红细胞体积的变异性较小。换句话说,红细胞在大小方面差异较小,呈现出相对均匀的特征。这可能是正常现象,也可能是某种疾病的表现。
二、红细胞变异系数偏低的可能原因
1. 贫血:贫血是最常见的导致红细胞变异系数偏低的原因之一。贫血是指体内红细胞数量或功能不足,造成血液中氧运输能力下降的疾病。若贫血的原因不是由于红细胞体积变异降低,则可能是红细胞的数量减少导致变异系数降低。
2. 肝脏疾病:肝脏是人体内重要的造血器官之一,在红细胞生成和分解过程中扮演重要角色。若肝脏功能出现异常,可能会影响红细胞形态和数量,导致变异系数偏低。
3. 部分遗传性疾病:一些遗传性血液疾病如球形红细胞性贫血等,会导致红细胞形态异常和数量减少,从而引起红细胞变异系数偏低。
三、如何处理红细胞变异系数偏低
1. 根据具体情况确定治疗方案:对于红细胞变异系数偏低的患者,医生需要综合考虑临床症状、病史及其他相关检查结果来确定治疗方案。如果是由于贫血所致,可以通过补充铁剂、维生素B12等进行治疗。
2. 定期复查:对于红细胞变异系数偏低的患者,定期复查可以帮助医生了解疾病的发展情况,及时调整治疗方案。
3. 预防为主:一些红细胞变异系数偏低的原因是可以预防的。保持良好的生活习惯,合理膳食搭配,多摄入富含铁质和维生素的食物,戒烟限酒,注意劳逸结合,有助于预防与红细胞变异系数偏低有关的疾病。
总之,红细胞变异系数偏低意味着红细胞体积的变异性较小,可能是正常现象,也可能是某种疾病的表现。通常情况下,医生需要综合考虑患者的临床症状和病史,结合其他相关检查结果,制定出科学有效的治疗方案。对于红细胞变异系数偏低的患者而言,定期复查和预防为主的生活方式都是至关重要的。通过科学的治疗和生活方式的调整,有助于改善患者的健康状况。
云作文原创内容,未经允许不得转载。